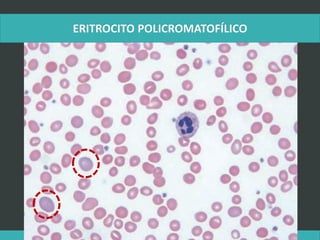
LATRODECTUS MACTANS 9
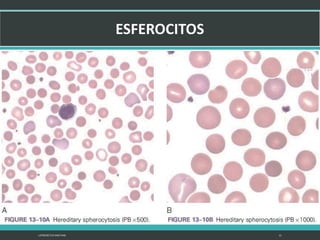
LATRODECTUS MACTANS 21
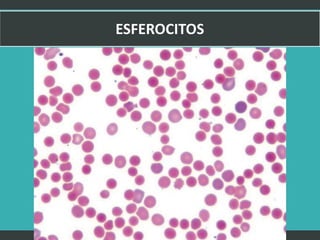
LATRODECTUS MACTANS 22
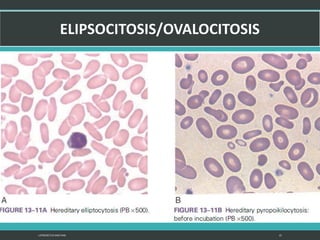
LATRODECTUS MACTANS 23
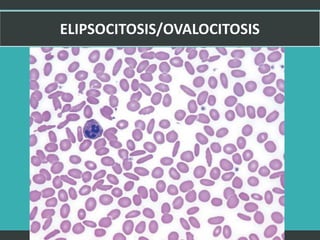
LATRODECTUS MACTANS 25
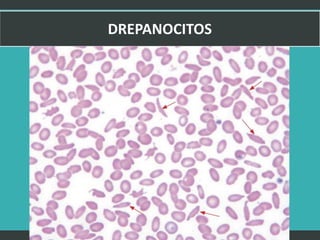
LATRODECTUS MACTANS 27
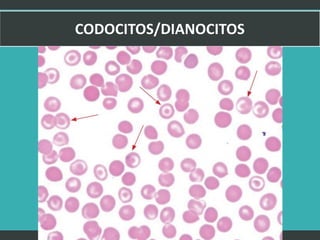
LATRODECTUS MACTANS 28
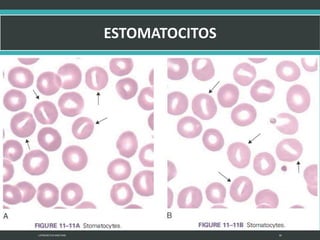
LATRODECTUS MACTANS 30
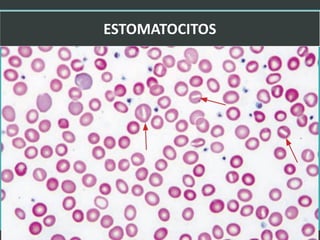
LATRODECTUS MACTANS 31
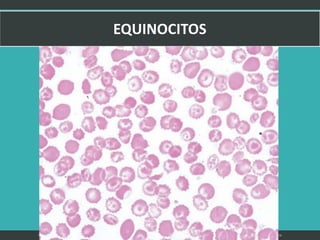
LATRODECTUS MACTANS 32
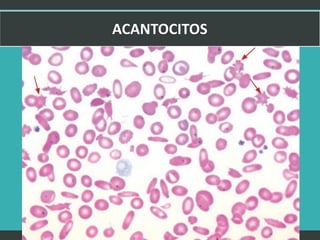
LATRODECTUS MACTANS 33
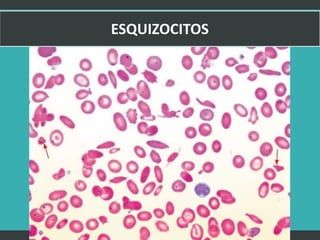
LATRODECTUS MACTANS 34
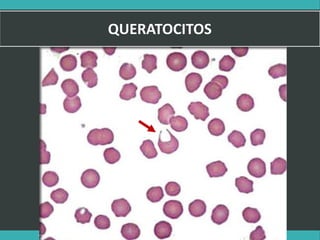
LATRODECTUS MACTANS 36

El documento describe las etapas de la hematopoyesis, incluyendo las características del proeritroblasto, eritroblasto basófilo, eritroblasto ortocromático y eritrocito. También describe las características de los principales tipos de leucocitos como el neutrófilo, eosinófilo y basófilo en sus diferentes etapas de desarrollo.